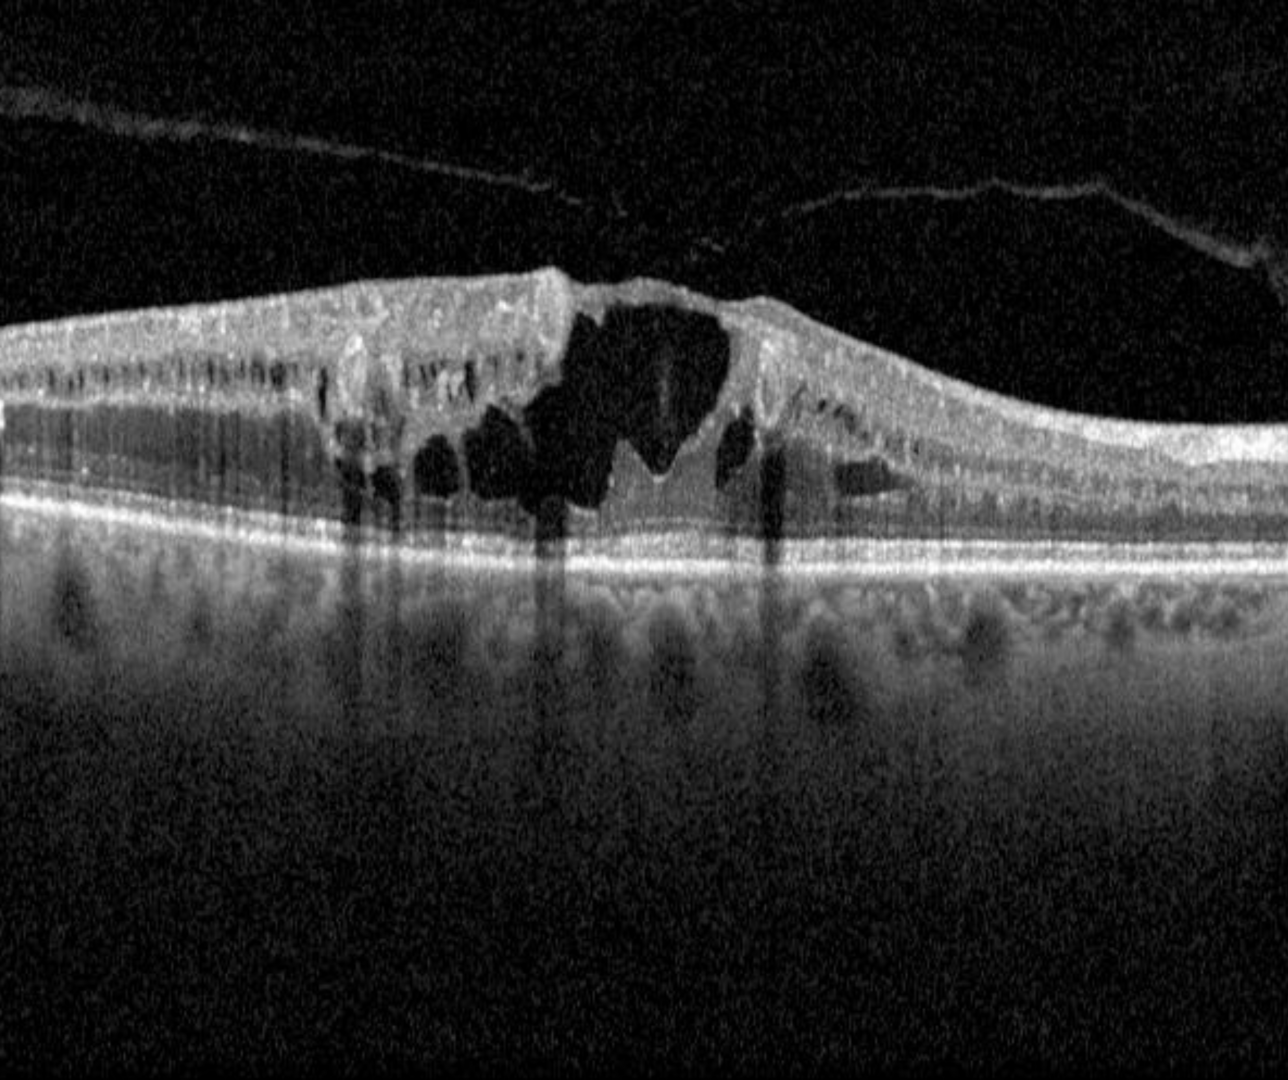

Overview
In diabetic patients, macular oedema may result from increased vascular permeability and breakdown of the blood retinal barrier. This causes leakage of lipids, proteins and serous fluid into the retina.
Signs of macular oedema may include both hard exudates (discrete, yellow-white lipid deposits) and retinal thickening or cystic spaces within either the inner and outer retinal layers. More advanced cases may present with subretinal oedema. For more information on each of these, please refer to the page "Diabetic retinopathy overview" - available using the link at the bottom of this page.
It is important to note that these two signs can exist independently of each other. If only hard exudates are present (no retinal thickening or cystic spaces), this indicates previous macular oedema. The presence of cystic spaces indicates current oedema, whether or not hard exudates are also present. For this reason, OCT is now considered an important part of a diabetic examination when diabetic macular oedema is suspected, however it should also be noted that diffuse retinal oedema may be difficult to detect on OCT imaging.
When describing diabetic macular oedema in this resource, we refer to the International Council of Ophthalmology guidelines (2017) which define centre-involving macular oedema as thickening within the central 1000µm of the macula. Macular oedema outside this region is described as non-centre-involving macular oedema.
It is important to note that macular oedema can occur at any level of diabetic retinopathy and can occur in the context of good visual acuity.
Also noteworthy is the fact that macular oedema may present in numerous other conditions including, but not limited to hypertensive retinopathy, retinal arterial macroaneuysm, Coats disease and choroidal neovascularisation. Links to each of these conditions are available at the end of this page.
Case Examples
-
Case 1: Centre-involving diabetic macular oedema
A 65-year-old Asian male who was diagnosed with type 2 diabetes 10 years previous. He is unsure of his latest HbA1c. His best corrected visual acuity in the right eye is 6/12-1 (20/40-1). This case will focus on the right eye only.
-
Case 2: Non-centre-involving macular oedema
A 50-year-old Caucasian female who was diagnosed with type 1 diabetes at the age of 17 and who is also being treated for systemic hypertension. Her most recent HbA1c was 8.2%. Her best corrected visual acuity was 6/6-1 (20/20-1) in the left eye. This case will focus on the left eye only.
-
Case 3: Centre-involving macular oedema
A 55 year old Caucasian male with best corrected visual acuity of 6/6 (20/20) in the right eye. He has type 2 diabetes and was diagnosed 7 years previously. He has not had a blood test for approximately 5 months but his last HbA1c was 7.5%.
Differential Diagnosis
Macular telangiectasia 2
Epiretinal membrane
Congenital optic disc pit maculopathy
Foveoschisis
Pachychoroid disease spectrum
Macular oedema associated with hypertensive retinopathy
Macular oedema associated with venous occlusion
References
Acón, Dhariana MD*; Wu, Lihteh MD† Multimodal Imaging in Diabetic Macular Edema, Asia-Pacific Journal of Ophthalmology: January 2018 - Volume 7 - Issue 1 - p 22-27
C.P Wilkinson, Frederick L Ferris, Ronald E Klein, Paul P Lee, Carl David Agardh, Matthew Davis, Diana Dills, Anselm Kampik, R Pararajasegaram, Juan T Verdaguer (2003). Proposed international clinical diabetic retinopathy and diabetic macular edema disease severity scales. Ophthalmology, Volume 110, Issue 9 - p 1677-1682
Tran, Khoi; Pakzad-Vaezi, Kaivon (2018) Multimodal imaging of diabetic retinopathy, Current Opinion in Ophthalmology: November - Volume 29 - Issue 6 - p 566-575


